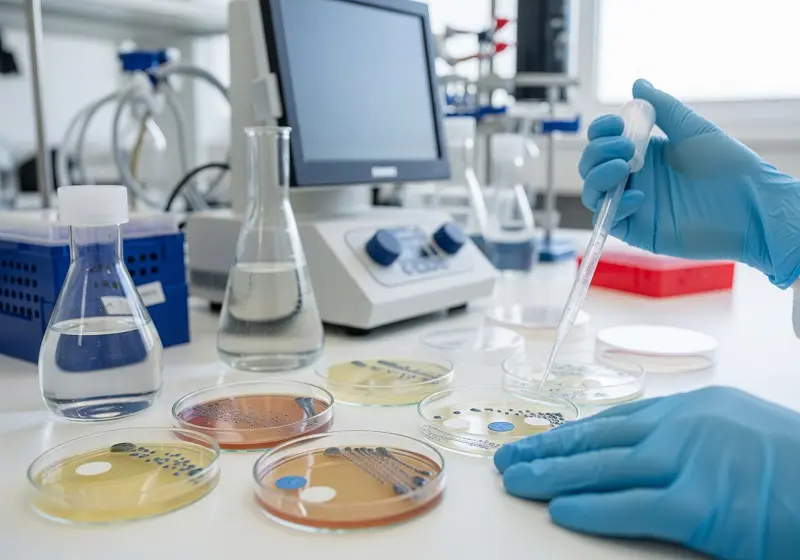

Este fenómeno ocurre cuando las bacterias y otros microorganismos desarrollan la capacidad de resistir los efectos de los medicamentos que antes los eliminaban o controlaban.
La Organización Mundial de la Salud (OMS) ha emitido reiteradas y cada vez más urgentes advertencias sobre una de las mayores amenazas para la salud global del siglo XXI: la resistencia a los antibióticos (RAM).
Imagen superior creada con IA en Google Ai Studio
Como resultado, las infecciones comunes se vuelven cada vez más difíciles, y en ocasiones imposibles, de tratar, lo que conduce a enfermedades prolongadas, mayor mortalidad y un aumento en los costos de atención médica.

¿Cómo Surge y se Propaga la Resistencia a los Antibióticos?
La resistencia a los antibióticos es un proceso natural de adaptación de las bacterias, pero su proliferación y aceleración se deben en gran medida a factores relacionados con las acciones humanas:
- Uso Indebido y Abuso de Antibióticos:
- En Medicina Humana: Prescripción innecesaria para infecciones virales (donde no son efectivos), no completar los ciclos de tratamiento y automedicación.
- En Ganadería y Agricultura: Uso masivo de antibióticos para promover el crecimiento de animales o prevenir enfermedades en cultivos, lo que crea un caldo de cultivo para bacterias resistentes que luego pueden transferirse a los humanos a través de la cadena alimentaria o el medio ambiente.
- Falta de Nuevos Antibióticos: La investigación y el desarrollo de nuevos antibióticos han disminuido drásticamente en las últimas décadas. Esto deja a la medicina con un arsenal limitado frente a las bacterias en evolución.
- Higiene y Saneamiento Deficientes: La falta de acceso a agua potable, saneamiento adecuado y prácticas de higiene básicas (como el lavado de manos) facilita la propagación de infecciones y, con ellas, de bacterias resistentes.
- Movilidad Global: El transporte rápido y la globalización permiten que las bacterias resistentes viajen rápidamente de un continente a otro. Así, se convierte un problema local en una crisis mundial en poco tiempo.

El Impacto de la Resistencia
Las consecuencias de la resistencia a los antibióticos son devastadoras:
- Infecciones Incurables: Enfermedades que antes eran fácilmente tratables, como la neumonía, la tuberculosis, la gonorrea y las infecciones urinarias, se vuelven incurables.
- Cirugías y Tratamientos de Riesgo: Procedimientos médicos vitales como cirugías, trasplantes de órganos, quimioterapia y el manejo de afecciones como la diabetes, que dependen de la eficacia de los antibióticos para prevenir infecciones, se vuelven extremadamente riesgosos.
- Aumento de la Mortalidad: Las infecciones resistentes causan aproximadamente 1.27 millones de muertes al año en el mundo, y se estima que esta cifra podría aumentar drásticamente si no se toman medidas.
- Carga Económica: El tratamiento de infecciones resistentes es más costoso debido a la necesidad de medicamentos de última generación, hospitalizaciones prolongadas y tratamientos complejos.
La Estrategia de la OMS: Un Enfoque Integral
La OMS aboga por una estrategia global y coordinada, conocida como «Una Salud», que involucre a todos los sectores (salud humana, sanidad animal, producción de alimentos y medio ambiente) para abordar la RAM. Las recomendaciones clave incluyen:
- Mejorar la Conciencia y la Educación: Informar al público y a los profesionales de la salud sobre la importancia del uso correcto de los antibióticos.
- Fortalecer la Vigilancia: Recopilar datos sobre la resistencia a los antibióticos para monitorear tendencias y guiar políticas.
- Reducir la Incidencia de Infecciones: Mejorar la higiene, el saneamiento, la vacunación y el control de infecciones en hospitales y comunidades.
- Optimizar el Uso de Antimicrobianos: Promover la prescripción responsable y el uso racional de antibióticos en humanos y animales.
- Aumentar la Inversión: Impulsar la investigación y el desarrollo de nuevos antibióticos, vacunas y herramientas de diagnóstico.

La resistencia a los antibióticos es una carrera contra el tiempo. La cooperación internacional y el compromiso de cada individuo son esenciales para preservar la eficacia de estos medicamentos vitales y evitar que el mundo regrese a una era pre-antibiótica donde las infecciones comunes eran a menudo sentencias de muerte.
Información relacionada en WebConsultas
Somos A Tu Salud… ¡Salud por todos los medios! ¡Síguenos en nuestras redes sociales!